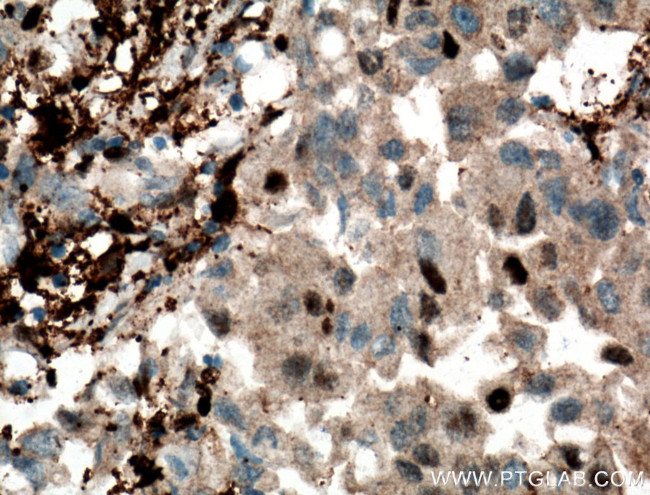
PD-ECGF Antibody in Immunohistochemistry (Paraffin) (IHC (P))
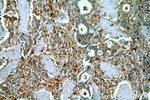
PD-ECGF Antibody in Immunohistochemistry (Paraffin) (IHC (P))

Search
Proteintech
PD-ECGF Polyclonal Antibody
{{$productOrderCtrl.translations['antibody.pdp.commerceCard.promotion.promotions']}}
{{$productOrderCtrl.translations['antibody.pdp.commerceCard.promotion.viewpromo']}}
{{$productOrderCtrl.translations['antibody.pdp.commerceCard.promotion.promocode']}}: {{promo.promoCode}} {{promo.promoTitle}} {{promo.promoDescription}}. {{$productOrderCtrl.translations['antibody.pdp.commerceCard.promotion.learnmore']}}
产品信息
12383-1-AP
种属反应
已发表种属
宿主/亚型
分类
类型
抗原
偶联物
形式
浓度
规格
纯化类型
保存液
内含物
保存条件
运输条件
产品详细信息
Immunogen sequence: MAALMTPGT GAPPAPGDFS GEGSQGLPDP SPEPKQLPEL IRMKRDGGRL SEADIRGFVA AVVNGSAQGA QIGAMLMAIR LRGMDLEETS VLTQALAQSG QQLEWPEAWR QQLVDKHSTG GVGDKVSLVL APALAACGCK VPMISGRGLG HTGGTLDKLE SIPGFNVIQS PEQMQVLLDQ AGCCIVGQSE QLVPAEGILY AARDVTATVD SLPLITASIL SKKLVEGLSA LVVDVKFGGA AVFPNQEQAR ELAKTLVGVG ASLGLRVAAA LTAMDKPLGR CVGHALEVEE ALLCMDGA (1-297 aa encoded by BC018160)
靶标信息
A platelet-derived endothelial growth factor (PD-ECGF), same as thymidine phosphorylase (TP) or gliostatin. In the presence of inorganic orthophosphate, it catalyses the reversible phospholytic cleavage of thymidine and deoxyuridine to their corresponding bases and 2-deoxyribose-1-phosphate. It is both chemotactic and mitogenic for endothelial cells and a non-heparin binding angiogenic factor present in platelets. It is also involved in transformation of fluoropyrimidines, cytotoxic agents used in the treatment of a variety of malignancies, into active cytotoxic metabolites.
仅用于科研。不用于诊断过程。未经明确授权不得转售。
生物信息学
蛋白别名: Gliostatin; OTTHUMP00000196767; OTTHUMP00000196770; PD TP; PD-ECGF; Platelet-derived endothelial cell growth factor; TdRPase; Thymidine phosphorylase; TP; unnamed protein product
基因别名: ECGF; ECGF1; hPD-ECGF; MEDPS1; MNGIE; MTDPS1; PDECGF; TP; TYMP
UniProt ID: (Human) P19971
Entrez Gene ID: (Human) 1890